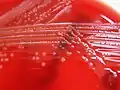

Listeria monocytogenes
| Listeria monocytogenes | ||
|---|---|---|
 Listeria monocytogenes | ||
| Taxonomía | ||
| Dominio: | Bacteria | |
| Reino: | Bacillati | |
| Filo: | Bacillota | |
| Clase: | Bacilli | |
| Orden: | Bacillales | |
| Familia: | Listeriaceae | |
| Género: | Listeria | |
| Especie: |
L. monocytogenes (E. Murray et al. 1926) Pirie 1940 | |
| serotipos | ||
| ||
Listeria monocytogenes es una especie de bacteria que se desarrolla intracelularmente y es causante de la listeriosis.[1][2] Es uno de los patógenos causante de infecciones alimentarias más violentos, con una tasa de mortalidad entre un 20 a 30 %, más alta que casi todas las restantes toxicoinfecciones alimentarias.[3] Listeria monocytogenes es un bacilo Gram positivo, pequeño (0,4 a 0,5 micrones de ancho × 0,5 a 1,2 de largo) no ramificado y anaerobio facultativo capaz de proliferar en una amplia gama de temperaturas (1 °C a 45 °C) y una elevada concentración de sal. Es catalasa positivo y no presenta cápsula ni espora. Tiene flagelos peritricos, gracias a los cuales presenta movilidad a 30 °C o menos, pero es inmóvil a 37 °C, temperatura a la cual sus flagelos se inactivan.[1][2][4]
Concepto
Listeria monocytogenes recibe su nombre del cirujano inglés Joseph Lister (Listeria) y de la capacidad de que extractos de su membrana estimulen la producción —generar— monocitos (monocytogenes) en el conejo, aunque no en la enfermedad del humano.[5]
Características
El género se encuentra definido por poseer un contenido de ADN G+C, aproximadamente de un 38% además en su membrana celular tiene una pared celular de mureina, péptidoglucano que contiene ácido meso-diaminopimélico que se encuentra fijo a la membrana celular por el ácido teicoico y el ácido lipoteicoico presentes en la membrana celular.
Puede ser aislada de diversos ambientes como suelo, agua fresca, aguas residuales y vegetación y puede llegar a infectar numerosos animales domésticos contaminando la vegetación y el suelo donde habitan. Es también un contaminante frecuente de los productos alimentarios, ya que es capaz de generar un biofilm en alimentos que se encuentren en refrigeración, porque tiene la capacidad de crecer hasta a 4 °C.[6]
La infección por Listeria monocytogenes, en el contexto del embarazo, suele diagnosticarse de forma tardía, produciéndose un cuadro muy grave, llamado granulomatosis infantiséptica, llegando a provocar abortos. También se ha relacionado con meningoencefalitis y meningitis especialmente en neonatos, ancianos e inmunodeprimidos, así como bacteriemia en mujeres gestantes, inmunodeprimidos y neonatos.

Patogenia
Listeria monocytogenes es un patógeno facultativo intracelular que puede crecer en los macrófagos, las células epiteliales y los fibroblastos en cultivo. Tras la ingesta de alimentos contaminados, Listeria monocytogenes puede sobrevivir a la exposición a enzimas proteolíticas, ácido gástrico y sales biliares.
Principalmente contiene dos proteínas de superficie conocidas como internalina A e internalina B las cuales interactúan con los receptores de las células del huésped para la adhesión celular. Los receptores se conocen como E-cadherina y Met (este último siendo el receptor del factor de crecimiento de hepatocitos o HGF) que inducen la fagocitosis. La internalina A es necesaria para la internalización en ciertas subpoblaciones de células epiteliales, mientras que la internalina B promueve la entrada a un mayor número de células. Ambas proteínas están reguladas por el operón inIAB.[7]
La presencia de internalinas facilita la entrada del microorganismo a las células. El organismo reacciona creando una especie de fagosoma con el fin de encapsular la bacteria pero ésta produce listeriolisina O y fosfolipasas C que le permiten destruir el fagosoma hidrolizando los lípidos de su membrana. Esta listeriolisina está codificada por el gen hly. Se ha demostrado además que la internalina B ayuda a la correcta formación de la vesícula de Listeria y a un escape vacular temprano reclutando proteínas como Rab7 o Vps34.[7] Al estar dentro del citosol Listeria monocytogenes utiliza una proteína de superficie denominada ActA la cual genera la polimerización intracelular de la actina. Aparte de ActA, L. monocytogenes usa la proteína InIC para desplazarse a la siguiente célula y para reducir la respuesta inmune del huésped. Todas estas proteínas de supervivencia intracelular, además del operón inIAB, están reguladas por el factor de transcripción PrfA.[6][7]
Estos filamentos se reorganizan en una larga cola que se extiende desde un solo extremo de la bacteria. Mediante los movimientos de la cola el microorganismo migra por el citoplasma hacia la membrana de la célula huésped. En la periferia se forman protrusiones (filópodos) que pueden penetrar en las células adyacentes y que permiten el ingreso de la bacteria. Esto explica la necesidad de una inmunidad mediada por células. Puesto que estos microorganismos nunca son extracelulares, los anticuerpos humorales del huésped no serían efectivos.[5]
Identificación microbiológica
| Cultivo en sangre de caballo de Listeria monocytogenes. |
| Cultivo en agar bilis esculina de Listeria monocytogenes. |
Listeria monocytogenes se desarrolla muy bien en agar sangre generando colonias grisáceas y presentando beta hemólisis. Es un bacilo catalasa positivo, móvil y se evidencia en medios de cultivo semisólido donde a los 25 °C el microorganismo forma una especie de sombrilla. Se desarrolla de manera adecuada en bilis, por lo que se utilizan medios inclinados con agar bilis esculina. Esta prueba consiste en determinar la capacidad que tiene Listeria monocytogenes de hidrolizar la esculina a esculetina y la glucosa en presencia de sales biliares. La esculetina generada reacciona con los iones de hierro que contiene el cloruro férrico en el medio y genera una coloración negra, siendo esta positiva.[6]
Listeria monocytogenes presenta un metabolismo fermentativo al generar ácido a partir de la glucosa y por producir acetona, lo que conlleva a una reacción de Voges-Proskauer positiva y no fermenta la xilosa. La fermentación de estos azúcares se evidencian por la técnica de Voges-Proskauer, la cual consiste en identificar si L. monocytogenes genera ácidos y diacetilo ya que el medio contiene azúcares fermentables. Para ver la reacción se utilizan los reveladores alfa-naftol y KOH. Si la suspensión se torna color rosa la prueba es positiva.[6]
La prueba de CAMP es utilizada para la identificación de Listeria monocytogenes Consiste en sembrar en agar sangre una estría en forma horizontal de Listeria monocytogenes y una perpendicular a esta de S. aureus sin unirse entre sí. El resultado esperado será que Listeria monocytogenes genere el factor CAMP el cual produce un sinergismo con la beta lisina producida por Staphylococcus aureus sobre los eritrocitos generando una lisis de estos.[10]
Tratamiento
Al ser la listeriosis una enfermedad relativamente rara en humanos, no hay estudios prospectivos y controlados que establezcan el mejor tratamiento antibiótico. Dado que la mayoría de los antibióticos son bacteriostáticos para Listeria monocytogenes, actualmente se considera que las mejores opciones son las combinaciones de gentamicina con penicilinas de espectro ampliado como la ampicilina.[5][11] Se han descrito fallos terapéuticos con estos antibióticos, pero nunca se ha demostrado in vitro resistencia al compuesto Antibiótico betalactámicoβ-lactámico utilizado. En el manejo de estas infecciones son de gran importancia el empleo de dosis altas y la duración adecuada del tratamiento, que deben individualizarse. En las enfermedades graves como la cerebritis o la granulomatosis infantiséptica, el inicio precoz del tratamiento es fundamental para el control de la infección. Estudios in vitro han demostrado sinergia de ampicilina y penicilina con aminoglucósidos. Esta asociación debe utilizarse en casos de granulomatosis infantiséptica o de sepsis neonatal. En aquellos pacientes con meningoencefalitis pueden asociarse aminoglucósidos, administrados por vía intratecal, al tratamiento base de penicilina o ampicilina.
La combinación de trimetoprim y sulfametoxazol se ha utilizado con éxito en pacientes alérgicos a penicilinas, considerándose en la actualidad la terapia alternativa en esta circunstancia.
La duración apropiada del tratamiento tampoco está clara. Tras dos semanas de terapia se han descrito recurrencias en pacientes inmunodeprimidos. Parece conveniente, por tanto, prolongar la terapia entre tres y seis meses en estos casos. En general dos semanas parecen ser suficientes en bacteriemias mientras que en meningitis se deberían utilizar ciclos más largos.[12]
Resistencia antibiótica
Listeria es resistente a las penicilinas naturales (penicilina G, penicilina V), penicilinas resistentes a β-lactamasa (meticilina, nafcilina, isoxazoilpenicilina—oxacilina, cloxacilina, dicloxacilina—) y a todas las cefalosporinas. Pero es susceptible a las penicilinas de espectro ampliado.[11][13]
Alternativas
Otras alternativas son cotrimoxazol, eritromicina, cloranfenicol, rifampicina, tetraciclinas, carbapenémicos, entre otros.
Igualmente, en agosto de 2006, la FDA (Food and Drug Administration) de Estados Unidos aprobó el uso de bacteriófagos en ciertas carnes con el fin de acabar con la bacteria Listeria monocytogenes.[14]
Profilaxis

Es necesario un control exhaustivo en todas las fases. En las empresas alimentarias se debe implantar un programa de autocontrol de los procesos según el Sistema APPCC:[16]
- En la granja hay que controlar el ensilado para que acidifique cuanto antes, porque en el medio ácido la bacteria se desarrolla muy mal.
- Almacenar la leche a menos de 4 °C, para evitar el desarrollo microbiano.[17]
- Durante el procesado de los alimentos se debe evitar la contaminación cruzada, evitando que contacten los alimentos ya cocinados con los crudos.
- El trabajador que tenga síntomas de padecer la enfermedad debe abstenerse de manipular alimentos.
- Se deben cocinar los alimentos a temperaturas elevadas y durante el tiempo suficiente, así mismo evitar consumir alimentos crudos.[5]
- Los vegetales se deben lavar y desinfectar si se van a consumir crudos.
- Es de suma importancia su control en la industria cárnica, evitando contaminaciones cruzadas de los canales con materias fecales durante el sacrificio de los animales.
- La bacteria crece con relativa facilidad a temperaturas bajas, por ello es importante que los equipos de refrigeración funcionen dentro de unos rangos de temperatura menores de 4 °C.[18][19]
Véase también
Referencias
- ↑ a b «Campylobacter and Listeria infections still rising in the EU – say EFSA and ECDC - European Food Safety Authority». www.efsa.europa.eu.
- ↑ a b https://efsa.onlinelibrary.wiley.com/doi/abs/10.2903/j.efsa.2015.4329
- ↑ Ramaswamy V; Cresence VM; Rejitha JS; Lekshmi MU; Dharsana KS; Prasad SP; Vijila HM. (febrero de 2007). «Listeria – review of epidemiology and pathogenesis.» (PDF). J. Microbiol. Immunol. Infect. 40 (1): 4-13. PMID 17332901. Archivado desde el original el 31 de marzo de 2020. Consultado el 5 de septiembre de 2010.
- ↑ Gründling A.; Burrack L.S.; Bouwer H.G.A.; Higgins D.E. (2004). «Listeria monocytogenes regulates flagellar motility gene expression through MogR, a transcriptional repressor required for virulence». Proc. Natl. Acad. Sci. U.S.A. 101 (33): 12316-12323. Bibcode:2004PNAS..10112318G. PMC 514476. PMID 15302931. doi:10.1073/pnas.0404924101.
- ↑ a b c d Patrick R. Murray; Ken S. Rosenthal; Michael A. Pfaller (Abril de 2009). «Capítulo 25: Listeria y Erysipelothrix». En Patrick R. Murray, ed. Microbiología Médica (6.ª edición). España: Elsevier-Mosby. pp. 225-260. ISBN 978-84-8086-465-7. OCLC 733761359. Consultado el 31 de marzo de 2012.
- ↑ a b c d Koneman, Elmer. Koneman diagnóstico microbiológico: texto y atlas en color, Ed. Sexta, p. 733, 735.
- ↑ a b c Cain, Robert J.; Scortti, Mariela; Monzó, Héctor J.; Vázquez-Boland, José A. (19 de enero de 2023). «Listeria InlB Expedites Vacuole Escape and Intracellular Proliferation by Promoting Rab7 Recruitment via Vps34». En Hultgren, Scott J., ed. mBio (en inglés): e03221-22. ISSN 2150-7511. doi:10.1128/mbio.03221-22. Consultado el 10 de febrero de 2023.
- ↑ Nathan Reading. «Listeria monocytogenes».
- ↑ Farber, J. M.; Peterkin, P. I. (septiembre de 1991). «Listeria monocytogenes, a food-borne pathogen». Microbiology and Molecular Biology Reviews 55 (3): 476-511. PMC 372831. PMID 1943998.
- ↑ Mac Faddin, Jean. Pruebas bioquímicas para la identificación de bacterias de importancia clínica, Ed. Médica Panamericana, p. 34.
- ↑ a b Chambers, Henry F.; Deck Daniel H. (2009) [Primera edición: 1982]. «Capítulo 43: Lactámicos β y otros antibióticos activos en la pared y al membrana celulares». Escrito en Estados Unidos. En Bertram G Katzung; Susan B Masters; Anthony J Trevor, eds. Farmacología básica y clínica. Lange médical book (11.ª edición). México: McGraw-Hill-Lange. pp. 773-793. ISBN 978-607-15-0336-7. OCLC 699461359.
- ↑ Genigeorgis C.; Carniciu M.; Dutulescu D.; Farver T.B. (1991). «Growth and survival of Listeria monocytogenes in market cheeses stored at 4 to 30 degrees C». J. Food Prot. 54 (9): 662-668.
- ↑ Seafood HACCP Alliance (2007). "Compendium of Fish and Fishery Product Processes, Hazards, and Controls, Chapter 15: Listeria monocytogenes". Archivado el 23 de junio de 2009 en Wayback Machine. Seafood Network Information Center, visto 28 de enero de 2009.
- ↑ Carlton, RM; Noordman, WH; Biswas, B; De Meester, ED; Loessner, MJ (2005). «Bacteriophage P100 for control of Listeria monocytogenes in foods: Genome sequence, bioinformatic analyses, oral toxicity study, and application». Regulatory Toxicology and Pharmacology 43 (3): 301-12. PMID 16188359. doi:10.1016/j.yrtph.2005.08.005.
- ↑ Presentan una nueva tecnología para detección rápida de patógenos en alimentos. citado el jueves 5 de abril de 2012
- ↑ «APPCC (Análisis de Peligros y Puntos de Control Crítico)». enero de 2019.
- ↑ Fleming D. W.; Cochi S. L.; MacDonald K. L.; Brondum J.; Hayes P. S.; Plikaytis B. D.; Holmes M. B.; Audurier A. et al. (1985). «Pasteurized milk as a vehicle of infection in an outbreak of listeriosis». N. Engl. J. Med. 312 (7): 404-407. PMID 3918263. doi:10.1056/NEJM198502143120704.
- ↑ M. D. Collins, S. Wallbanks, D. J. Lane, J. Shah, R. Nietupskin, J. Smida, M. Dorsch and E. Stackebrandt. Phylogenetic Analysis of the Genus Listeria Based on Reverse Transcriptase Sequencing of 16S rRNA. International J. of Systematic and Evolutionary Microbiology, abril de 1991 v. 41 Nº. 2 240–246
- ↑ Gray M. L.; Killinger A. H. (1966). «Listeria monocytogenes and listeric infection». Bacteriol. Rev. 30: 309-382.
Enlaces externos
 Wikimedia Commons alberga una categoría multimedia sobre Listeria monocytogenes.
Wikimedia Commons alberga una categoría multimedia sobre Listeria monocytogenes. Wikispecies tiene un artículo sobre Listeria monocytogenes.
Wikispecies tiene un artículo sobre Listeria monocytogenes.- U.S. Food and Drug Administration. Foodborne Pathogenic Microorganisms and Natural Toxins Handbook: Listeria monocytogenes
- Public Health Agency of Canada
- Type strain of Listeria monocytogenes at BacDive - the Bacterial Diversity Metadatabase